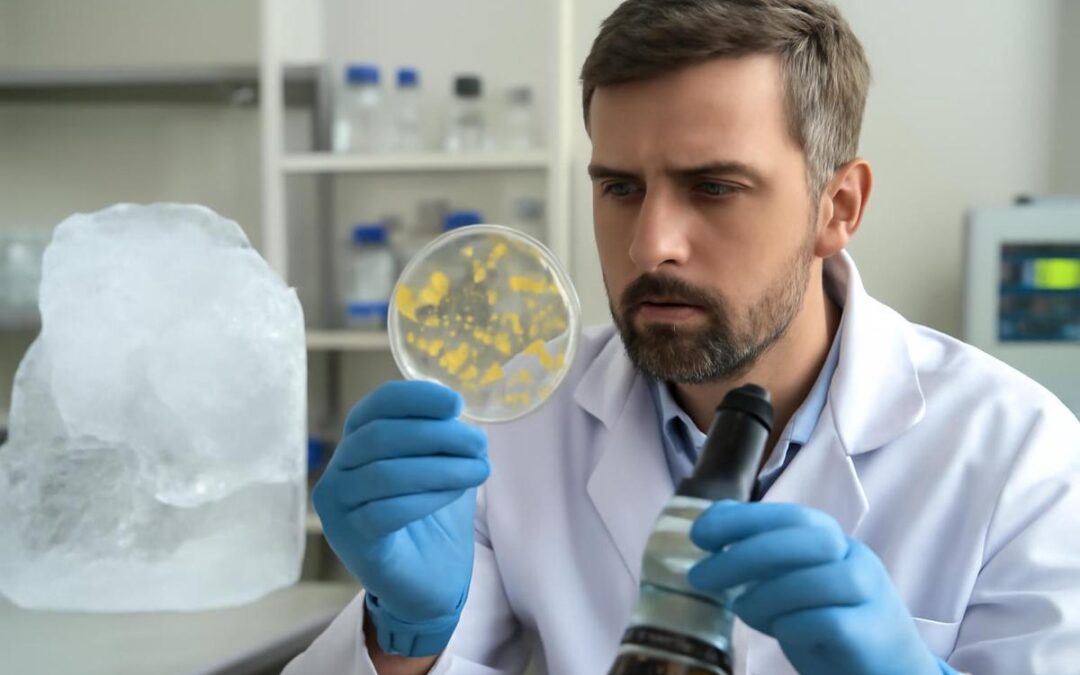
Bacterias de una cueva de hielo de 5,000 años desafían a los antibióticos modernos

por Super 107.5 | Feb 26, 2026 | Noticias
Científicos de la Universidad de Witwatersrand y la Universitat Autònoma de Barcelona avanzaron en la manipulación de la luz cuántica, creando estados de alta dimensión que pueden transportar más información por fotón. Un equipo de físicos de la Universidad de...

por Super 107.5 | Feb 26, 2026 | Noticias
Un estudio revela que los adultos mayores que evitan la carne podrían tener menos probabilidades de llegar a los 100 años, aunque esto se relaciona principalmente con aquellos que son delgados y frágiles. Un reciente estudio indicó que los adultos mayores que evitan...

por Super 107.5 | Feb 26, 2026 | Noticias
El programa del 20 de febrero de Lo Que Viene recibió a María Fernanda Indorado y Santiago Valenti, organizadores de Gastro POP, quienes presentaron los próximos eventos gastronómicos que realizarán y explicaron cómo formar parte de su comunidad para acceder a...

por Super 107.5 | Feb 22, 2026 | Noticias
Científicos hallaron en una cueva de hielo de Rumania una bacteria que, a pesar de su antigüedad, muestra resistencia a antibióticos modernos y podría ofrecer nuevas oportunidades en biotecnología. Las bacterias son organismos extraordinariamente adaptables, capaces...

por Super 107.5 | Feb 22, 2026 | Noticias
Investigadores noruegos encontraron que aumentar el nivel del agua en tierras de turba del Ártico puede reducir drásticamente las emisiones de CO2, convirtiendo estas áreas en sumideros de carbono. Las tierras de turba del Ártico, que alguna vez fueron grandes...

Comentarios recientes